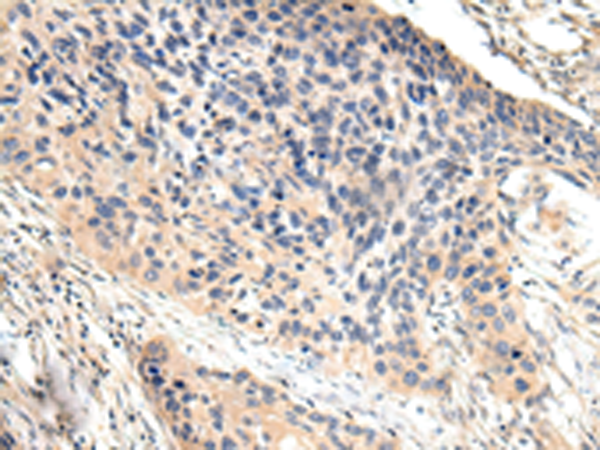
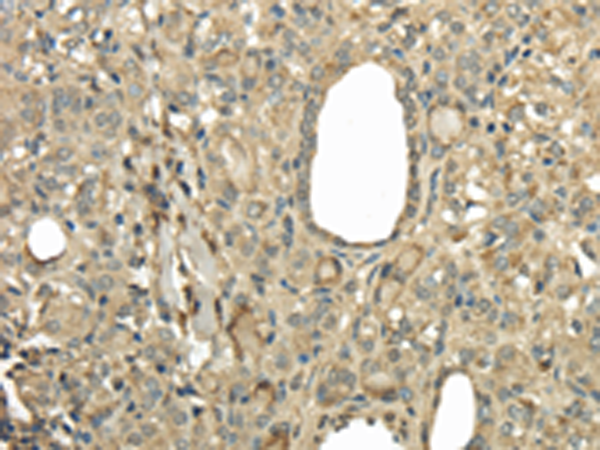
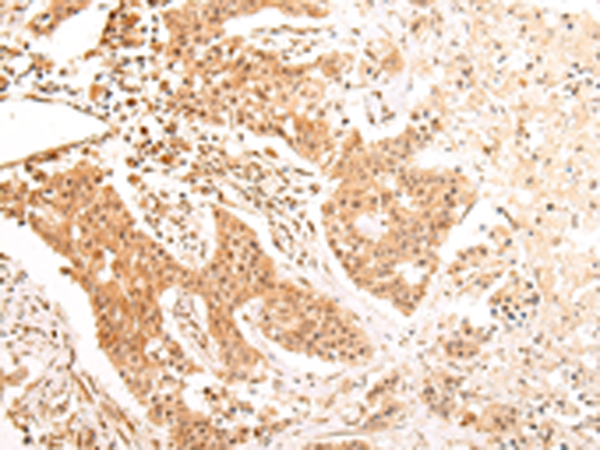

-
分类: 科研抗体货号: P08968别名: CD106; INCAM-100应用: IHC反应种属: Human, Mouse, Rat
-
分类: 科研抗体货号: P08950别名: HSPC321; SWAP-70应用: IHC反应种属: Human, Mouse
-
分类: 科研抗体货号: P08933别名: HR6B; UBC2; HHR6B; RAD6B; E2-17kDa应用: IHC反应种属: Human, Mouse, Rat
-
分类: 科研抗体货号: P08967别名:应用: WB反应种属: Human, Mouse
-
分类: 科研抗体货号: P08949别名: DLTA; PDCE2; PDC-E2应用: WB,IHC反应种属: Human, Mouse, Rat
-
分类: 科研抗体货号: P08932别名: D8; UBE2; UBA1B; UBE1L应用: IHC反应种属: Human
-
分类: 科研抗体货号: P08947别名: SLS; FALDH; ALDH10应用: WB,IHC反应种属: Human
-
分类: 科研抗体货号: P08966别名: KIAA1036应用: WB,IHC反应种属: Human, Mouse
-
分类: 科研抗体货号: P08931别名: NICE-4应用: IHC反应种属: Human, Mouse
-
分类: 科研抗体货号: P08946别名: ST1; MDA9; SYCL; MDA-9; TACIP18应用: WB,IHC反应种属: Human, Mouse, Rat

鄂公网安备42018502007531号
鄂公网安备42018502007531号

